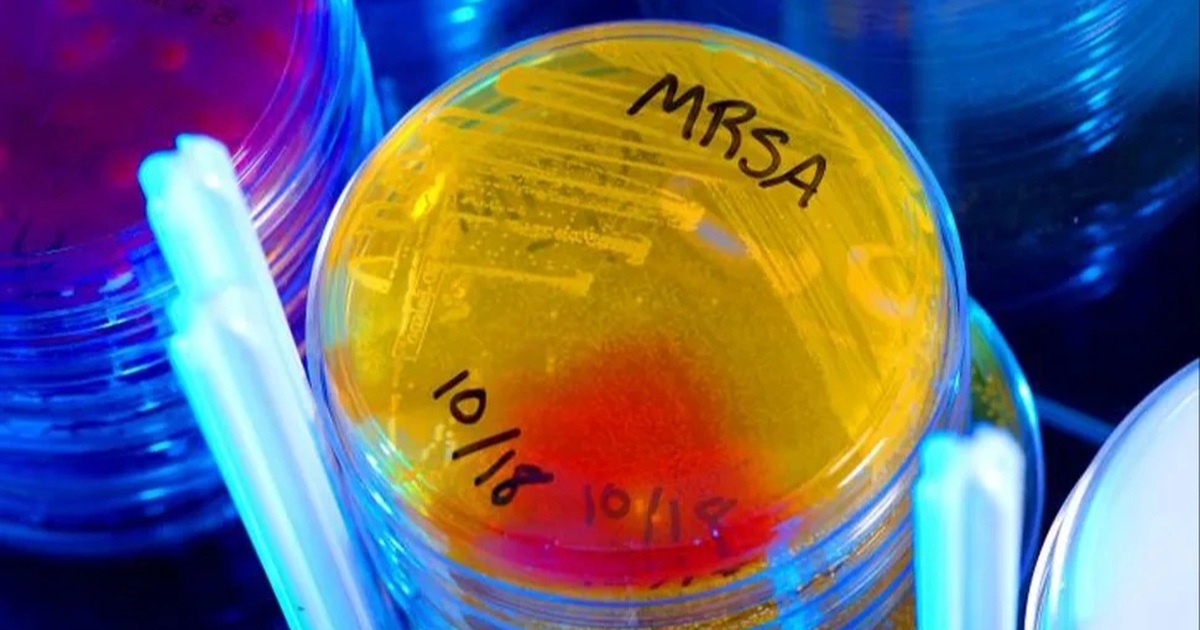

(Dân trí) - Một nghiên cứu bất ngờ vừa hé lộ một loại kháng sinh hoàn toàn mới, có thể trở thành cứu cánh trong cuộc chiến với các bệnh nhiễm trùng kháng thuốc.
Loại kháng sinh mới được tìm thấy khi các nhà nghiên cứu đang tìm hiểu cách 1 loại thuốc cũ hoạt động. Trong quá trình đó, họ tình cờ phát hiện ra một hợp chất chưa từng được biết đến.
Hợp chất này có khả năng tiêu diệt các chủng vi khuẩn “khó nhằn” như Staphylococcus aureus kháng methicillin (MRSA) và Enterococcus faecium vốn là những nguyên nhân gây ra nhiễm trùng nặng ở bệnh viện và ngày càng khó điều trị bằng thuốc hiện tại.
Điều đặc biệt là hợp chất mới này được tạo ra từ một loại vi khuẩn sống trong đất. Dù có nguồn gốc từ tự nhiên, hợp chất này lại sở hữu khả năng kháng khuẩn vượt trội và tỏ ra hiệu quả hơn nhiều lần so với kháng sinh gốc được nghiên cứu ban đầu.
Từ nghiên cứu cơ bản đến “mỏ vàng” lặn dưới đất
Nhóm nghiên cứu do 2 nhà khoa học Lona Alkhalaf và Greg Challis dẫn đầu bắt đầu công trình của mình với mục tiêu tìm hiểu cơ chế tạo ra một loại kháng sinh đã được biết đến có tên là methylenomycin A.
Loại kháng sinh này được sản xuất bởi vi khuẩn đất Streptomyces coelicolor. Họ không tìm kiếm kháng sinh mới mà chỉ muốn hiểu cách vi khuẩn tạo ra thuốc.
Vi sinh vật, bao gồm vi khuẩn và nấm, có khả năng sản sinh ra hàng ngàn hợp chất phức tạp. Nhiều hợp chất trong số đó đã trở thành thuốc điều trị cho con người, như thuốc kháng sinh, thuốc chống ung thư hay thuốc chống ký sinh trùng.
Bằng cách tìm hiểu cách các hợp chất này hình thành trong tự nhiên, các nhà khoa học có thể phát triển các loại thuốc mới có hiệu quả hơn và ít tác dụng phụ hơn.
Trong vi khuẩn, các hợp chất sinh học thường được tạo ra từ những nhóm gen cụ thể được gọi là cụm gen sinh tổng hợp. Nhóm nghiên cứu đã tiến hành loại bỏ một số gen trong cụm này để quan sát quá trình tạo ra methylenomycin A bị gián đoạn như thế nào.
Khi phản ứng bị chặn lại giữa chừng, các sản phẩm trung gian bắt đầu xuất hiện. Trong số đó có 2 hợp chất chưa từng được ghi nhận trước đây.
Một trong hai hợp chất mới này, có tên gọi là pre-methylenomycin C lactone, cho thấy hoạt tính kháng khuẩn rất mạnh khi thử nghiệm trên các chủng vi khuẩn Gram dương.
Đặc biệt, hợp chất này tiêu diệt hiệu quả MRSA và Enterococcus faecium - 2 loại vi khuẩn vốn rất khó điều trị vì đã kháng lại nhiều loại thuốc thông thường.
Hoạt tính vượt trội và dấu ấn chống kháng thuốc
Không chỉ mạnh hơn methylenomycin A khoảng 100 lần trong việc tiêu diệt vi khuẩn, pre-methylenomycin C lactone còn có một ưu điểm rất đáng chú ý.
Qua thử nghiệm kéo dài 28 ngày, vi khuẩn không phát triển khả năng kháng lại loại thuốc mới.
Trong thử nghiệm, vi khuẩn Enterococcus faecium được tiếp xúc liên tục với hợp chất mới ở liều lượng tăng dần. Đây là điều kiện lý tưởng để vi khuẩn học cách chống lại thuốc.
Tuy nhiên, kết quả cho thấy nồng độ ức chế tối thiểu vẫn không thay đổi suốt quá trình thử nghiệm. Điều đó có nghĩa là hợp chất này vẫn duy trì hiệu quả diệt khuẩn mà không bị vi khuẩn “lờn thuốc”.
Đây là một bước tiến quan trọng bởi hiện nay, tình trạng kháng kháng sinh đang khiến nhiều bệnh nhiễm trùng trở nên khó điều trị hơn bao giờ hết. Khi 1 loại thuốc mới xuất hiện và không dễ bị vi khuẩn kháng lại, đó là một tín hiệu tốt cho y học.
Dù vậy, giới khoa học vẫn tỏ ra thận trọng. Theo nhà hóa học Stephen Cochrane từ Đại học Queen’s Belfast, người không tham gia nghiên cứu, có một sự khác biệt rất lớn giữa một hợp chất có khả năng diệt khuẩn trong phòng thí nghiệm và một loại thuốc thực sự được đưa vào sử dụng.
Ông cho biết: “Một loại thuốc để được chấp thuận sử dụng cho người cần phải đảm bảo nhiều tiêu chí như không gây độc, ổn định trong cơ thể và có hiệu quả lâm sàng rõ rệt”.
Mở ra hướng đi khác trong điều trị vi khuẩn kháng thuốc
Sau khi phát hiện ra tiềm năng của pre-methylenomycin C lactone, nhóm nghiên cứu đã lên kế hoạch phát triển hợp chất này thành thuốc.
Hiện tại, họ đang hợp tác với nhà hóa học David Lupton tại Đại học Monash, Úc để tìm cách tổng hợp hợp chất này trong phòng thí nghiệm thay vì phải dựa vào vi khuẩn để tạo ra nó.
Nếu thành công, họ có thể sản xuất hợp chất với số lượng lớn, từ đó phục vụ cho các nghiên cứu sâu hơn về cách thức hoạt động của nó và các tác động lên tế bào người.
Điều này cũng mở ra khả năng điều chỉnh cấu trúc hóa học của hợp chất để tạo ra các biến thể có hiệu lực cao hơn hoặc ít tác dụng phụ hơn.
Nhóm nghiên cứu cho biết bước tiếp theo là xác định mục tiêu sinh học của hợp chất này trong cơ thể vi khuẩn và phân tích xem thay đổi nhỏ trong cấu trúc phân tử có thể làm tăng hay giảm hiệu quả diệt khuẩn như thế nào.
Những hiểu biết đó sẽ là nền tảng để phát triển thêm các loại kháng sinh cùng nhóm, giúp y học có thêm vũ khí mới trong cuộc chiến chống vi khuẩn kháng thuốc.
Tuy còn nhiều việc phải làm nhưng phát hiện này cho thấy tự nhiên vẫn còn nhiều bí mật chưa được khám phá. Trong thời điểm nhiều loại thuốc mất dần hiệu lực, thì một hợp chất mới, hiệu quả và chưa bị kháng lại có thể là điều ngành y tế đang chờ đợi.